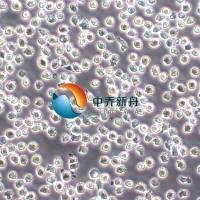
NALM6 B系急性淋巴细胞白血病细胞

相关产品推荐更多 >
万千商家帮你免费找货
0 人在求购买到急需产品
- 详细信息
- 询价记录
- 技术资料
- 库存:
99
- 英文名:
FMG
- 供应商:
复蒙
- 规格:
T25
| 移动电话:18917685907, 18917685969, 18917685929 | |
| 公司电话:021-5126-2076 | |
| 以下是实验室部分细胞,如果有细胞方面需要,请电话或邮件咨询. | |
| HUVEC | 人脐静脉内皮细胞 |
| Colo205 | 人结肠癌细胞, |
| RSMC | 大鼠主动脉平滑肌细胞 |
| caco-2 | 人结肠癌细胞 |
| YAC-1 | 小鼠淋巴瘤细胞 |
| KB | 人口腔上皮癌细胞 |
| H22 | 小鼠肝癌细胞 |
| 3T3-L1 | 小鼠胚胎成纤维细胞 |
| HK-2 | 人近曲小管上皮细胞 |
| att-20 | 小鼠垂体瘤细胞 |
| BV-2 | 小鼠小胶质瘤细胞 |
| A375 | 人皮肤黑色素瘤细胞 |
| A431 | 人皮肤基底细胞癌 |
| A549 | 人肺癌细胞 |
| A875 | 人黑色素瘤细胞 |
| BeWo | 人胎盘绒毛癌细胞 |
| BGC-823 | 人胃腺癌细胞 |
| BT474 | 人乳腺导管瘤 |
| CACO-2 | 人结肠癌细胞 |
| CaLu-3 | 人肺腺癌细胞 |
| CASKI, | 人宫颈癌 |
| Colo205 | 人结肠癌 |
| Colo320DM | 人结肠癌 |
| D341 Med | 人髓母细胞瘤 |
| Daudi | 人B淋巴细胞瘤 |
| DU145 | 人前列腺癌细胞 |
| G-401 | 人肾癌Wilms |
| GLC-82 | 人肺腺癌细胞 |
| HCT116 | 人结直肠癌 |
| HCT-8 | 人结肠腺癌 |
| HEC-1B | 人子宫内膜癌细胞 |
| Hela | 人宫颈癌细胞 |
| Hep G2 | 人肝癌细胞 |
| Hep-2 | 人喉癌细胞 |
| HL-60 | 人白血病细胞 |
| HOS | 人骨肉瘤细胞 |
| HT-1080 | 人纤维肉瘤 |
| HT-29 | 人结肠腺癌细胞 |
| HuTu-80 | 人十二脂肠腺癌 |
| JEG-3 | 人绒癌细胞 |
| Jurkat E6-1 | 人T细胞淋巴瘤 |
| Jurkat77 | 人T淋巴瘤细胞亚系 |
| K562 | 人红白血病细胞 |
| KB | 人口腔上皮癌 |
| LoVo | 人结肠癌 |
| M17 | 人神经母细胞瘤 |
| MCF7 | 人乳腺癌细胞 |
| MCF7B | 人乳腺癌细胞 |
| MDA-MB-157 | 人乳腺癌细胞 |
| MDA-MB-231 | 人乳腺癌细胞 |
| MDA-MB-435s | 人乳腺癌细胞 |
| MDA-MB-453 | 人乳腺癌细胞 |
| MG-63 | 人骨肉瘤细胞 |
| MOLT-4 | 人淋巴细胞白血病细胞 |
| NCI-H157 | 人非小细胞肺腺癌 |
| NCI-H209 | 人小细胞肺癌 |
| NCI-H446 | 人小细胞肺癌 |
| NTERA-2 | 人恶性多发性畸胎瘤细胞 |
| PA-1 | 人卵巢畸胎瘤细胞 |
| PANC-1 | 人胰腺癌细胞 |
| PC-3 | 人前列腺癌细胞 |
| RAJI | 黑人Burkitt淋巴瘤 |
| RAMOS | 人B淋巴细胞瘤 |
| RAMOS(RA.1) | 人B淋巴细胞瘤 |
| RPMI-8226 | 人多发骨髓瘤细胞 |
| SaOS-2 | 人骨肉瘤细胞 |
| SF126 | 人脑瘤 |
| SF17 | 人脑瘤 |
| SF763 | 人脑瘤 |
| SF767 | 人脑瘤 |
| SH-SY5Y | 人骨髓神经母细胞瘤 |
| SK-BR-3 | 人乳腺癌细胞 |
| SK-MEL-1 | 人皮肤黑色素瘤细胞 |
| SK-N-SH | 人神经母细胞瘤 |
| SK-OV-3 | 人卵巢腺瘤细胞 |
| SMMC-7721 | 人肝癌细胞 |
| SW13 | 人肾上腺皮质瘤 |
| SW480 | 人结直肠癌 |
| T84 | 人结肠癌细胞 |
| THP1 | 人单核细胞型淋巴瘤 |
| U-2 OS | 人骨肉瘤细胞 |
| U251 | 人神经胶质细胞瘤 |
| U-937 | 人淋巴瘤细胞 |
| ZR-75-1 | 人乳腺导管癌 |
| A498 | 人肾癌细胞 |
| C33A | 人宫颈癌细胞 |
| Hela 229 | 人宫颈癌细胞 |
| Hela P10s-11F | 人宫颈癌细胞 |
| 3T3 swiss | swiss鼠胚胎成纤维细胞 |
| 3T3L1 | 小鼠胚胎成纤维细胞(前脂肪) |
| 3T6swiss | 小鼠胚胎成纤维细胞 |
| BHK-21 | 金黄地鼠肾 |
| BS-C-1 | 非注洲绿猴肾 |
| C2C12 | 小鼠成肌细胞 |
| C3H 10T1/2 2A6 | 小鼠成纤维细胞 |
| CHOdhfr | 二氢叶酸缺陷型中国仓鼠卵巢细胞 |
| CHO-K1 | 中国仓鼠卵巢细胞 |
| COS-1 | 非洲绿肾 |
| COS-7 | 非洲绿猴肾细胞 |
| CV-1 | 猴肾细胞 |
| IAR20 | 小鼠肝细胞 |
| IEC-6 | 大鼠小肠隐窝上皮细胞 |
| LL-PK1, | 猪肾细胞 |
| MC3T3-E1 | 小鼠胚胎成骨细胞 |
| MDCK | 狗肾细胞 |
| MEF | 小鼠胚胎成纤维细胞 |
| NIH3T3 | 小鼠胚胎成纤维细胞 |
| P815 | 小鼠肥大细胞 |
| PA12 | 小鼠成纤维细胞 |
| RTE | 大鼠气管上皮细胞 |
| SMC | 兔主动脉平滑肌细胞 |
| Vero | 猴肾细胞 |
| WEHI-3 | 小鼠血液细胞 |
| Y2 | 小鼠成纤维细胞 |
| L6 | 大鼠骨骼肌成肌细胞 |
| NRK | 小鼠结缔组织细胞 |
| AtT-20 | 小鼠垂体瘤 |
| BC3H1, | 鼠脑瘤 |
| BV-2 | 小鼠小胶质瘤细胞636元,DMEM高糖+10%胎牛血清 |
| C6 | 大鼠脑胶质瘤 |
| EL-4 | 鼠T淋巴细胞瘤 |
| FOX-NY | 小鼠淋巴瘤细胞 |
| GH3 | 大鼠垂体瘤细胞 |
| GT1.1 | 小鼠垂体瘤细胞(分泌促生长激素分泌激素) |
| HEPA1-6 | 小鼠肝癌细胞 |
| MEL | 小鼠红白血病细胞 |
| MFC | 小鼠前胃癌细胞 |
| MMQ | 大鼠垂体瘤细胞 |
| NG108-15 | 小鼠神经细胞瘤/大鼠神经胶质细胞瘤杂交瘤细胞 |
| P19 | 小鼠畸胎瘤细胞 |
| PC-12 | 大鼠嗜铬细胞瘤细胞 |
| RAW264.7 | 小鼠巨噬细胞瘤636元+DMEM高糖 |
| SP2/0-AG14 | 小鼠骨髓瘤 |
| Yac-1 | 小鼠淋巴瘤细胞 |
| H-4-II-E | 大鼠肝细胞瘤 |
| L1210 | 小鼠淋巴细胞白血病 |
| RBL-1 | 大鼠嗜碱性粒细胞白血病 |
| MV-1-Lu | 鼬肺上皮细胞 |
| 移动电话:18917685907, 18917685969, 18917685929 | |
| 公司电话:021-5126-2076 | |
风险提示:丁香通仅作为第三方平台,为商家信息发布提供平台空间。用户咨询产品时请注意保护个人信息及财产安全,合理判断,谨慎选购商品,商家和用户对交易行为负责。对于医疗器械类产品,请先查证核实企业经营资质和医疗器械产品注册证情况。
- 作者
- 内容
- 询问日期
技术资料暂无技术资料 索取技术资料
犬肾(MDCK)细胞
询价